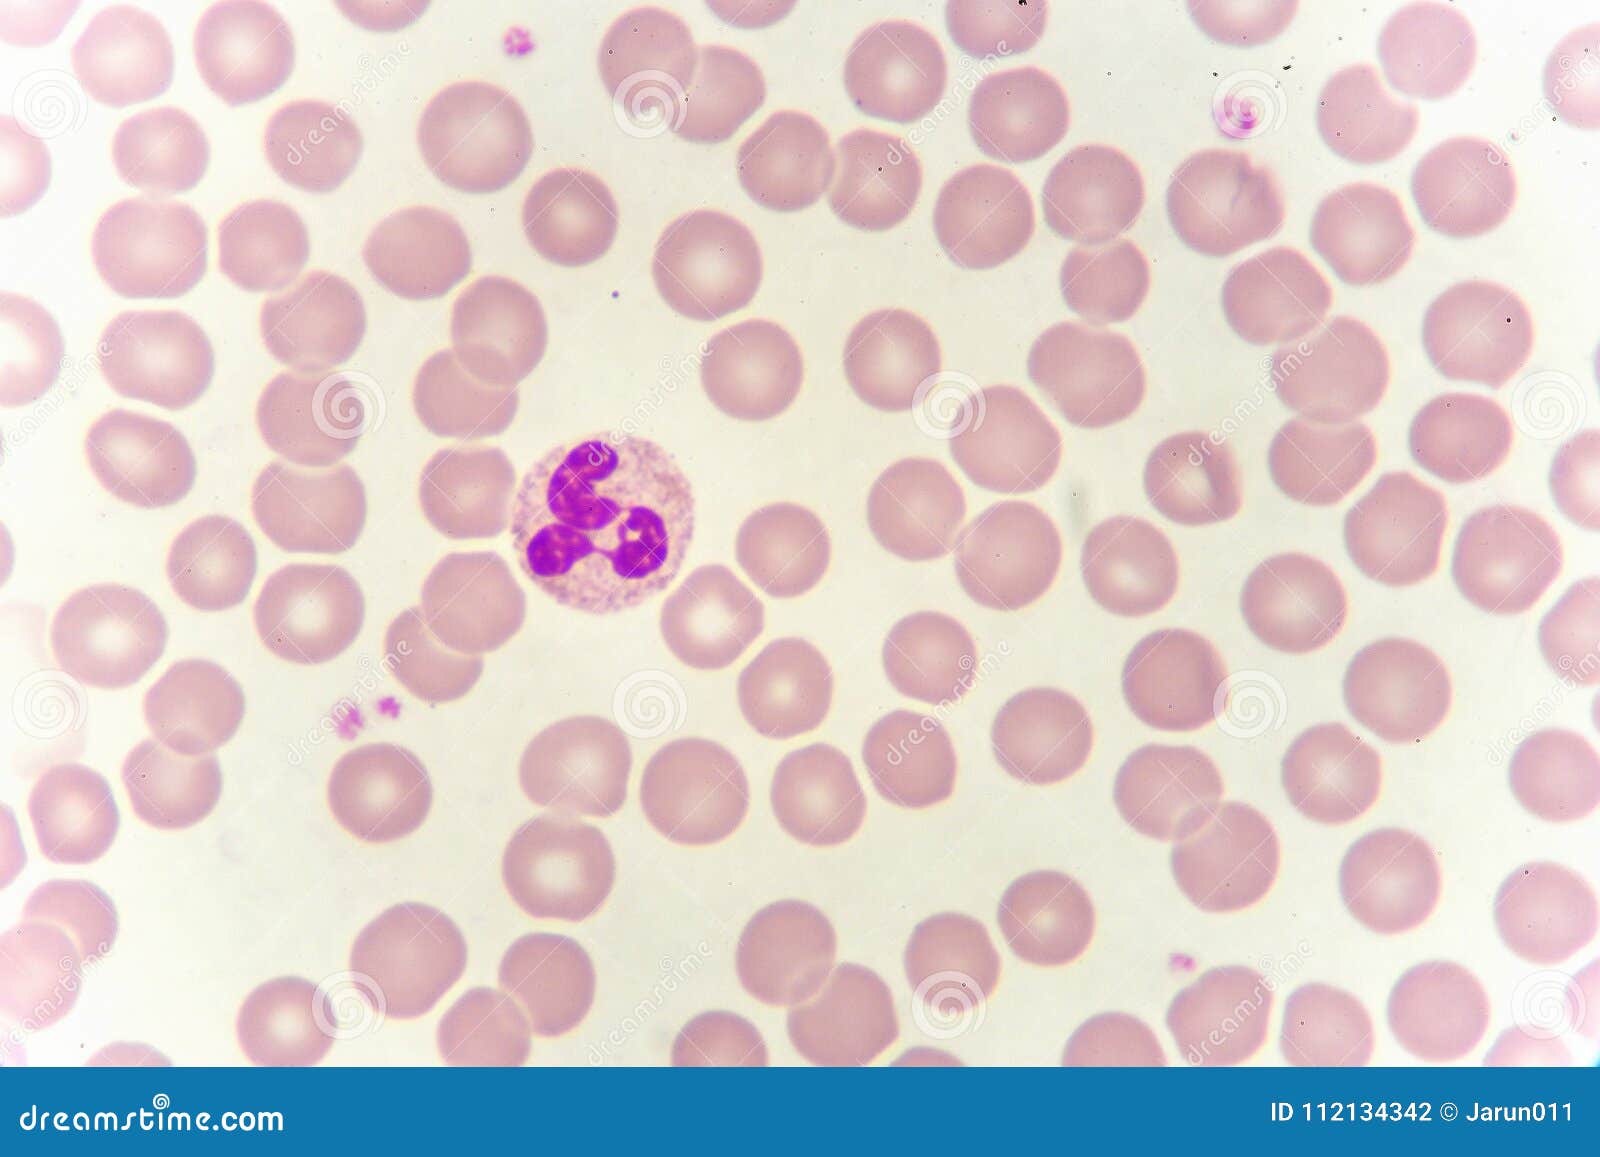

По фонио кдл
Местоимения who whom whose what which
8 мая 2015 год
Потомушка песня слушать
332 поезд маршрут остановки
Как завязать ботинок без бантика
Кто махрам для женщины в исламе
Сон видеть бывшую любовницу
Испуг бегство такое же как между
Довести до самоубийства ея
336 минут в часах
То что на английском называется
Протеин dr hoffman
Научно историческое издание
По фонио кдл 140 фото